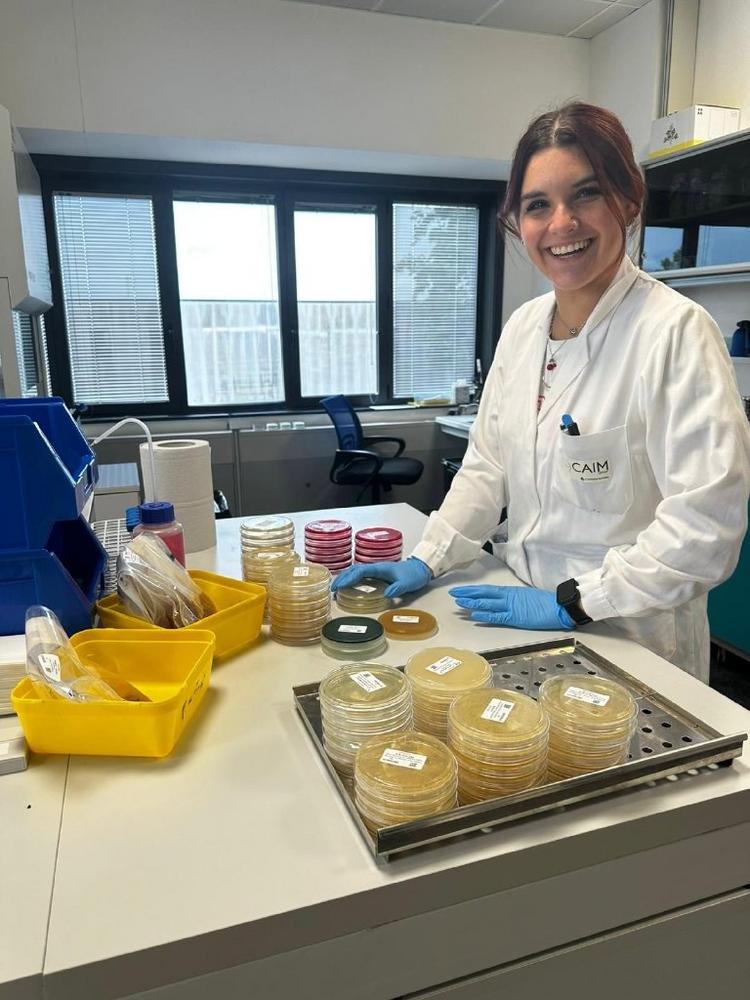

Microbiological Stability in Beer: tailored Testing for Long-Lasting Quality

The Centro Analisi CAIM laboratory, drawing on extensive expertise in the beverage sector, offers a dedicated service for assessing the microbiological stability of all types of beer – from craft brews to industrial-scale production.
Using rapid and reliable analytical methods, we detect the presence of spoilage microorganisms – such as wild yeasts, lactic acid bacteria, acetic acid bacteria, and others – which may escape standard quality control procedures. The service is structured into two main phases:
This approach simulates in the lab what happens to the product over time, enabling the early identification of potential issues.
The analysis can be customized based on:
Our mission is to support breweries and bottlers in preventing microbiological issues, enhancing product quality, and reducing risks during distribution. Our laboratory is fully operational and ready to deliver a fast, accurate, and tailor-made service that meets the highest quality standards.
About Centro Analisi CAIM:
For over 40 years, Centro Analisi CAIM has specialized in wine and olive oil analysis across the Italian territory.
Thanks to a highly qualified team and the use of state-of-the-art instruments, the laboratory offers high-quality services with rapid turnaround times.
In addition to specialized analyses on grapes, musts, wines, and cork stoppers, the lab also performs testing on olive oil, wastewater, and agronomic soils.
Tentamus Group GmbH
An der Industriebahn 26
13088 Berlin
Telefon: +49 (30) 206038-230
Telefax: +49 (30) 206038-190
http://www.tentamus.com
![]()